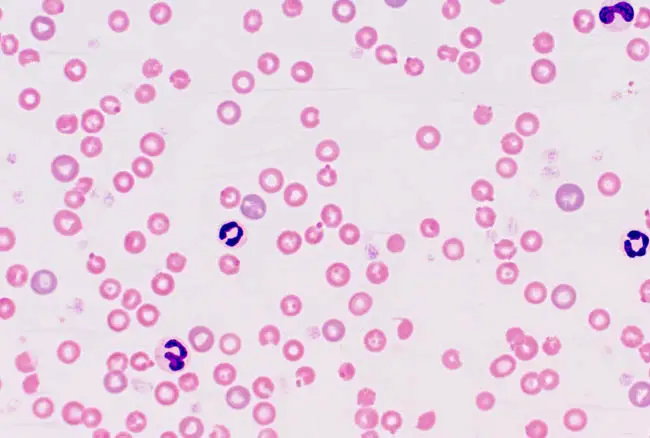

A macskák nem tudnak enni hagymát ( Fokhagyma ) Vagy bármely más tag Ő - Ő Család . Ő - Ő SPPTioszulfin Josulfonate). Az interaktív oxidálókhoz kapcsolódó kén -oxidáció, amelyek vezethetnek Heinz Heinz test vérszegénység .
Heinz teste rendellenes struktúrák, amelyek a hemoglobin megváltozása után alakulnak ki, amely a fehérje, amely az oxigént a vörösvértestekbe szállítja. Általában a hemoglobin súlyos és szervezett, de ha kén oxidációnak vannak kitéve, a csoport csoportja és annak formái megváltoznak, úgynevezett Heinz. Heinz teste kicsi, kerek vagy szabálytalan a vörösvértestekben, amikor mikroszkópot néznek. A Heinz testek jelenléte megakadályozhatja a vörösvértestek természetes működését, például az oxigén átvitelét, és a sejteket törékenyebbé és emollis (törés) lehet.
A fokhagyma a legmérgezőbb szerv Ő - Ő Család, however, all Ő - Ő A macskák fajai mérgezőek. Még olyan termékek is, amelyek fokhagymát, hagymát, hagymát, port és sót tartalmaznak. A legtöbb macska nem fogyaszt hagymát csak erős szaguk miatt. A kiállítás akkor fordulhat elő, ha a macska figyelmeztetése olyan termék, amely hagymát vagy fokhagymát tartalmaz, mint gyermekek számára, amelyet általában beteg macskáknak adnak.
Klinikai jelek
- Mimbran nyálkahártya sápadt: Az íny, a belső szemhéjak és más nyálkahártya membránok sápadtnak tűnhetnek a vörösvértestek számának csökkenése miatt.
- Gyengeség vagy inaktivitás: A vörösvértestek kis száma és a szövetek oxigénellátásának későbbi csökkentése gyengeséget és letargiát okozhat.
- Tachipnea: Amikor a vörösvértestek esnek, a tüdő kompenzálja a több oxigén elérésének kísérletét.
- Expresszió: A vörösvértestek esetében bilirubinnak nevezett festéket bocsátanak ki, amely felhalmozódhat és sárga bőrt és szemet okozhat a szemében.
- Megnövekedett szív- és légzési sebesség: Az alacsony oxigén-, szív- és légzési átvitel kompenzálásának kísérlete növekedhet.
- Sötét vizelet: Mivel a bilirubin kiválasztódik a vizeletben, sötét vagy barna vizeletet okozhat.
- Emésztőrendszeri rendellenességek: hasi fájdalom, étvágyvesztés, nagymama, hasmenés és hányás.
A klinikai tünetek több napot is igénybe vehetnek, mivel a vörösvértestek gyorsabban vesznek el, mint a test helyettesítheti őket. Nem minden, a testben vérszegénységet tartalmazó macska nem jelenik meg ezeknek a klinikai tüneteknek, és a jelek súlyossága a vérszegénység mértékétől függően változhat. Ha azt gyanítja, hogy kutyája macskája hagymát vagy fokhagymát evett, azonnal keresse meg az állatorvosi figyelmet.
Bukás
Az állatorvos teljes fizikai vizsgálatot végez, és kórtörténetét fog végezni. Ez magában foglalja a tünetek időtartamát, és a modern ételek elfogyasztották a macskát, és ha a macska előírt vagy előírt gyógyszereket kap.
Diagnosztikai munkára van szükség a vérsejtek számának ellenőrzéséhez és a szervek működésének értékeléséhez.
Diagnosztikai munka:
- Basy teszt: Biokémiai fájl A tag funkciójának értékelése érdekében, Emokróm És a vizeletanalízis. A CBC kis számú vörösvértestet fedezhet fel.
- Vérmenekülés: Egy üveg pengén keresztül meghosszabbítja a vért, és mikroszkóp alatt vizsgálják a vörösvértestek méretének és alakjának kiértékelésére, valamint a Heinz testek jelenlétének megkeresésére. MEGJEGYZÉS: A macskáknak lehetnek Heinz -teste vérvörösvértestekben vérszegénység nélkül.
Uralkodik
Ha a nyelés nemrégiben van, az állatorvos stimulálja a hányást, majd az aktivált szén követi a fennmaradó toxinnal való kommunikációt. Sajnos a legtöbb macska az expozíció után néhány napig nem alakul ki klinikai tüneteket.
A Transzfúzió Szükséges lesz a súlyos vérszegénységben szenvedő macskák számára. A vérben lévő vércsoportnak ugyanolyannak kell lennie, mint a recipient. A legtöbb állatorvosi gyakorlat macskával rendelkezik egy rezidens gyakorlathoz, amelyet adományozhat.
Az oxigén adható az alacsony forgalmazott oxigén szintjének kompenzálására.
Vénás folyadékok a vesék kiszáradásának és védelmének kezelésére vagy megelőzésére.
Mit csinálsz, ha a macskád hagymát eszik
Ha a macskája hagymát, hagymát vagy más alwaumot eszik, vegye fel a kapcsolatot az állatorvosával. Az azonnali orvosi kezelés jobb eredményt eredményez, mivel az állatorvos kiküszöböli az emésztőrendszer szennyeződését az felszívódás elkerülése érdekében. Miután a hagyma felszívódott, az egyetlen kezelés kedvező.
Mennyi a macskák mérgező hagyma?
5 gramm / kilogramm fogyasztás Elegendő a vér klinikai változásainak ragaszkodása. Nyilvánvaló, hogy a hagyma elfogyasztja a macskát, és minél több kockázatot jelent. De a macskáknak nem szabad enni olyan ételt, amely hagymát tartalmaz, még a legtöbb hagyma is végzetes lehet. Az alábbi kép a kis 5 gramm hagymát mutatja. Ez a szilva méretének egy kis hagyma része volt.

milyen macska az a garfield
védelem
A macskák nem fiatalok, és sok olyan élelmiszer és gyógyszer, amely biztonságos számunkra, végzetes lehet a macskák számára.
- Н хранят с котки, които ъъъат л, чеъъ или многогодишен чеъъ. Nincs biztonságos korlát, és még a kis expozíció is végzetes lehet.
- Mindig olvassa el a termékmatricákat. Még az olyan ételek is, amelyek ártalmatlannak tűnnek, mint például a gyermekek és a fűszerek, tartalmazhatnak hagymát, fokhagymát vagy termékeket.
- Ne hagyja az ételt ellenőrzés nélkül bankokban vagy asztalokban.
- Az anaikus macskák esetében a konzerv tonhal vagy a csirkemell gőzzel kedvezőbb, mint a bébiétel, amely általában hagymát és fokhagymát tartalmaz.
- Mindig konzultáljon egy állatorvoshoz, mielőtt a macskáknak bármilyen kiegészítőt vagy a számú gyógyszert adna.
- Ha hagymát, fokhagymát, fokhagymát vagy fokhagymát termeszt a kertben, fedje le a biztonságos madarakat, hogy távol tartsa a macskát.
Ha macskája hagymát vagy fokhagymát fogyaszt, azonnal keresse meg az állatorvosi figyelmet.











![Hány éves a cicám? [Egy illusztrált útmutató]](https://mycats.pet/img/about-cats/94/how-old-is-my-kitten-an-illustrated-guide.webp)
![Hogyan kezeljük az ótvart macskákban [Inc. a takarítási rendszer]](https://mycats.pet/img/health/82/how-to-deal-with-ringworm-in-cats-inc-the-housecleaning-regime.webp)

